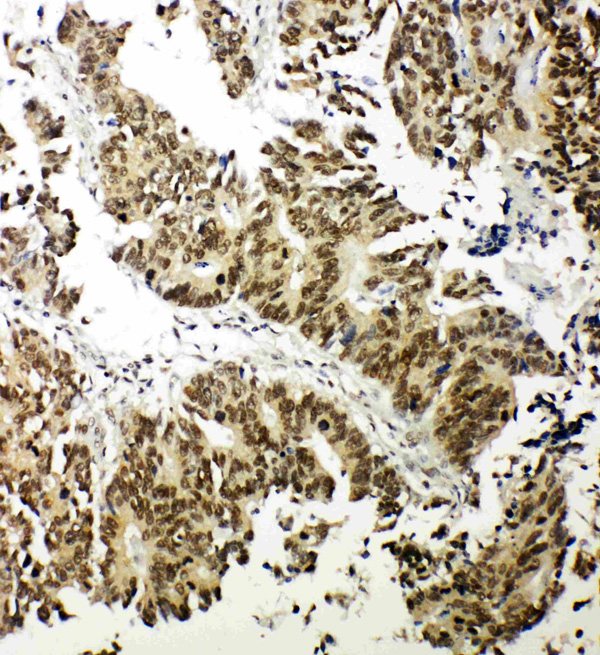
product-image-AAA45410_IHC8.jpg

Nuclear respiratory factor 1 Recombinant Protein | Nrf1 recombinant protein
Recombinant Mouse Nuclear respiratory factor 1
Gene Names
Nrf1; C87038; D6Ertd415e
Purity
Greater or equal to 85% purity as determined by SDS-PAGE.
Synonyms
Nuclear respiratory factor 1; N/A; Recombinant Mouse Nuclear respiratory factor 1; NRF-1; Alpha palindromic-binding protein; Alpha-pal; Nrf1 recombinant protein
Host
E Coli or Yeast or Baculovirus or Mammalian Cell
Purity/Purification
Greater or equal to 85% purity as determined by SDS-PAGE.
Form/Format
Lyophilized or liquid (Format to be determined during the manufacturing process)
Sequence Positions
1-503. Full Length
Sequence
MEEHGVTQTEHMATIEAHAVAQQVQQVHVATYTEHSMLSADEDSPSSPEDTSYDDSDILNSTAADEVTAHLAAAGPVGMAAAAAVATGKKRKRPHVFESNPSIRKRQQTRLLRKLRATLDEYTTRVGQQAIVLCISPSKPNPVFKVFGAAPLENVVRKYKSMILEDLESALAEHAPAPQEVNSELPPLTIDGIPVSVDKMTQAQLRAFIPEMLKYSTGRGKPGWGKESCKPIWWPEDIPWANVRSDVRTEEQKQRVSWTQALRTIVKNCYKQHGREDLLYAFEDQQTQTQATTTHSIAHLVPSQTVVQTFSNPDGTVSLIQVGTGATVATLADASELPTTVTVAQVNYSAVADGEVEQNWATLQGGEMTIQTTQASEATQAVASLAEAAVAASQEMQQGATVTMALNSEAAAHAVATLAEATLQGGGQIVLSGETAAAVGALTGVQDANGLVQIPVSMYQTVVTSLAQGNGPVQVAMAPVTTRISDSAVTMDGQAVEVVTLEQ
Species
Mus musculus (Mouse)
Preparation and Storage
Store at -20 degree C, for extended storage, conserve at -20 degree C or -80 degree C.
Related Product Information for Nrf1 recombinant protein
Transcription factor that activates the expression of the EIF2S1 (EIF2-alpha) gene. Links the transcriptional modulation of key metabolic genes to cellular growth and development. Implicated in the control of nuclear genes required for respiration, heme biosynthesis, and mitochondrial DNA transcription and replication
Product Categories/Family for Nrf1 recombinant protein
References
"Coding sequence, chromosomal localization, and expression pattern of Nrf1: the mouse homolog of Drosophila erect wing." Schaefer L., Engman H., Miller J.B. Mamm. Genome 11:104-110(2000)
NCBI and Uniprot Product Information
NCBI GeneID
Molecular Weight
55.6 kDa
NCBI Official Synonym Full Names
nuclear respiratory factor 1
NCBI Official Symbol
Nrf1
NCBI Official Synonym Symbols
C87038; D6Ertd415e
NCBI Protein Information
nuclear respiratory factor 1
UniProt Protein Name
Nuclear respiratory factor 1
UniProt Gene Name
Nrf1
UniProt Synonym Gene Names
NRF-1; Alpha-pal
UniProt Entry Name
NRF1_MOUSE
Customer Reviews
Loading reviews...
Share Your Experience
Similar Products
Product Notes
The Nrf1 nrf1 (Catalog #AAA116612) is a Recombinant Protein produced from E Coli or Yeast or Baculovirus or Mammalian Cell and is intended for research purposes only. The product is available for immediate purchase. The immunogen sequence is 1-503. Full Length. The amino acid sequence is listed below: MEEHGVTQTE HMATIEAHAV AQQVQQVHVA TYTEHSMLSA DEDSPSSPED TSYDDSDILN STAADEVTAH LAAAGPVGMA AAAAVATGKK RKRPHVFESN PSIRKRQQTR LLRKLRATLD EYTTRVGQQA IVLCISPSKP NPVFKVFGAA PLENVVRKYK SMILEDLESA LAEHAPAPQE VNSELPPLTI DGIPVSVDKM TQAQLRAFIP EMLKYSTGRG KPGWGKESCK PIWWPEDIPW ANVRSDVRTE EQKQRVSWTQ ALRTIVKNCY KQHGREDLLY AFEDQQTQTQ ATTTHSIAHL VPSQTVVQTF SNPDGTVSLI QVGTGATVAT LADASELPTT VTVAQVNYSA VADGEVEQNW ATLQGGEMTI QTTQASEATQ AVASLAEAAV AASQEMQQGA TVTMALNSEA AAHAVATLAE ATLQGGGQIV LSGETAAAVG ALTGVQDANG LVQIPVSMYQ TVVTSLAQGN GPVQVAMAPV TTRISDSAVT MDGQAVEVVT LEQ. It is sometimes possible for the material contained within the vial of "Nuclear respiratory factor 1, Recombinant Protein" to become dispersed throughout the inside of the vial, particularly around the seal of said vial, during shipment and storage. We always suggest centrifuging these vials to consolidate all of the liquid away from the lid and to the bottom of the vial prior to opening. Please be advised that certain products may require dry ice for shipping and that, if this is the case, an additional dry ice fee may also be required.Precautions
All products in the AAA Biotech catalog are strictly for research-use only, and are absolutely not suitable for use in any sort of medical, therapeutic, prophylactic, in-vivo, or diagnostic capacity. By purchasing a product from AAA Biotech, you are explicitly certifying that said products will be properly tested and used in line with industry standard. AAA Biotech and its authorized distribution partners reserve the right to refuse to fulfill any order if we have any indication that a purchaser may be intending to use a product outside of our accepted criteria.Disclaimer
Though we do strive to guarantee the information represented in this datasheet, AAA Biotech cannot be held responsible for any oversights or imprecisions. AAA Biotech reserves the right to adjust any aspect of this datasheet at any time and without notice. It is the responsibility of the customer to inform AAA Biotech of any product performance issues observed or experienced within 30 days of receipt of said product. To see additional details on this or any of our other policies, please see our Terms & Conditions page.Item has been added to Shopping Cart
If you are ready to order, navigate to Shopping Cart and get ready to checkout.